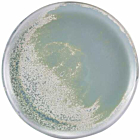

SKU
NV0611
| Units | 1 x 6 |
|---|
Genware Porcelain Organic Triangular Bowl 18.5cm/7.25"
In stock
£56.45
£47.04
SKU
NV0611
| Units | 1 x 6 |
|---|
£56.45
£47.04
In stock
Visually appealing curvaceous shape, unique and complimentary to the porcelain range. Conforms to BS4034 for vitrified hotelw
| PLEASE NOTE THIS PRODUCT CANNOT BE COLLECTED FROM THOMAS RIDLEY. IT WILL BE DELIVERED DIRECT TO YOU WITHIN 3-5 DAYS, WITH A £5 DELIVERY CHARGE. THERE IS A MINIMUM SUPPLIER VALUE OF £60 FOR PRODUCT CODES THAT START WITH NV |
ALWAYS READ THE LABEL:
Ingredients (Inc Allergens) can and do change.Here at Thomas Ridley we are continually updating our product database, and make every effort to ensure accurate Allergen data for each product line. If you are concerned about allergens we would always recommend you check the product label before use.
Amount Per 100g Serving
Energy
mono-unsaturates
0g
polyunsaturates
0g
transfats
0g
polyols
0g
starch
0g
non milk
0g
Cholesterol
0g
| Weight (Kg) | 14.500000 |
|---|---|
| Pack Size | 6 |
See more
Neville
You might also like to try...